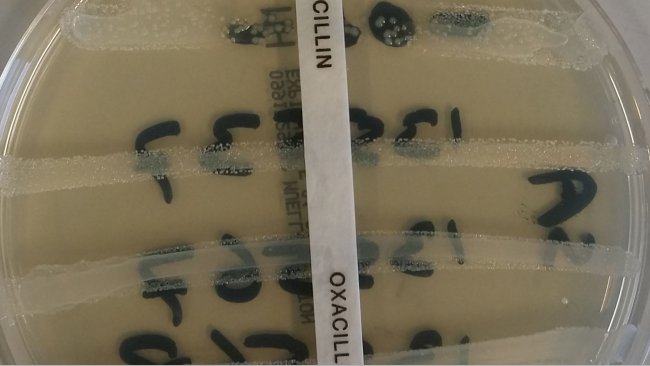
resistência antimicrobiana

O AMCRA (Centro de Conhecimento sobre o uso de antibióticos e resistência em animais) quer reduzir ainda mais o uso total de antibióticos em animais na Bélgica. O novo acordo de antibióticos 2021-2024, assinado pelo ministro federal da agricultura, David Clarinval, e pelo ministro federal da saúde pública, Frank Vandenbroucke, tem quatro novos objectivos.
Em 2016, a AMCRA assinou o primeiro acordo com o governo federal com o objetcivo de abordar estruturalmente o uso de antibióticos em animais. Foram definidas três metas principais de redução: reduzir para metade o uso total de antibióticos em animais até 2020, reduzir o uso dos antibióticos de uso crítico em 75% até 2020 e reduzir para metade as rações medicamentosas com antibióticos até 2017.

Os resultados provisórios mostraram que o sector estava no caminho certo para cumprir as metas. No final de 2019, já havia uma redução de 40,3% no uso total de antibióticos. O uso de antibióticos de importância crítica caiu até 77,3% e o uso de ração animal medicamentosa com antibióticos caiu 71,1%.
Estes resultados positivos impulsionaram o sector a dar mais um passo. O novo acordo inclui quatro novos objectivos:
- uso total máximo de 50 mg por kilo de biomassa até ao final de 2024, o que corresponde a uma redução de 65% em comparação com 2011 (uma diminuição adicional de 15% em 4 anos);
- reducir o uso de colistina a um máximo de 1 mg por kg de biomassa para 2024;
- o sector das rações para animais quer focar-se numa diminuição de 75% para 2024;
- reducir a menos de 1% nos consumidores habituais (porcos, frangos de engorda, vitelos).
25 de Fevereiro de 2021/ VILT/ Bélgica.
https://vilt.be/nl/